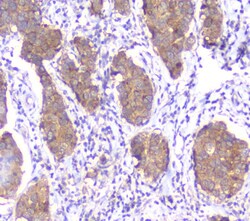
Invitrogen SMN1/SMN2 Monoclonal Antibody (2B10) 100 &mu;g; Unconjugated:Antibodies,

Learn More
Invitrogen™ SMN1/SMN2 Monoclonal Antibody (2B10)


Mouse Monoclonal Antibody
Brand: Invitrogen™ MA527878
Description
Reconstitute with 0.2 mL of distilled water to yield a concentration of 500 μg/mL. Positive Control - WB: human Hela whole cell, human placenta tissue, human SW620 whole cell, human PANC-1 whole cell, human HepG2 whole cell, human A549 whole cell, rat RH35 whole cell, mouse HEPA1-6 whole cell. IHC: human mammary cancer tissue, human mammary cancer tissue. ICC/IF: A431 Cell.
The SMN1 gene is part of a 500 kb inverted duplication on chromosome 5q13. This duplicated region contains at least four genes and repetitive elements which make it prone to rearrangements and deletions. The repetitiveness and complexity of the sequence have also caused difficulty in determining the organization of this genomic region. The telomeric and centromeric copies of this gene are nearly identical and encode the same protein - survival motor neuron protein. The SMN complex plays a catalyst role in the assemble of small nuclear ribonucleoproteins, the building blocks of the spliceosome. Mutations in the SMN1 gene are known to cause spinal muscular atrophy 1/2.
Specifications
| SMN1/SMN2 | |
| Monoclonal | |
| 500 μg/mL | |
| PBS with 4mg trehalose and 0.05mg sodium azide | |
| O35876, P97801, Q16637 | |
| SMN1 | |
| A synthetic peptide corresponding to a sequence at the N-terminus of human SMN1/2 (22-52aa RRGTGQSDDSDIWDDTALIKAYDKAVASFKH). | |
| 100 μg | |
| Primary | |
| Human, Mouse, Rat | |
| Antibody | |
| IgG1 |
| Immunohistochemistry, Immunohistochemistry (Paraffin), Western Blot, Immunocytochemistry | |
| 2B10 | |
| Unconjugated | |
| SMN1 | |
| AI849087; BCD541; component of gems 1; Gemin1; Gemin-1; SMA; SMA@; SMA1; SMA2; SMA3; SMA4; Smn; SMN1; SMN2; SMNC; SMNT; survival motor neuron 1; survival motor neuron 1 protein; survival motor neuron protein; survival of motor neuron 1, telomeric; survival of motor neuron protein; T-BCD541; TDRD16A; tudor domain containing 16A | |
| Mouse | |
| Antigen affinity chromatography | |
| RUO | |
| 20595, 64301, 6606 | |
| -20°C | |
| Lyophilized |
Your input is important to us. Please complete this form to provide feedback related to the content on this product.